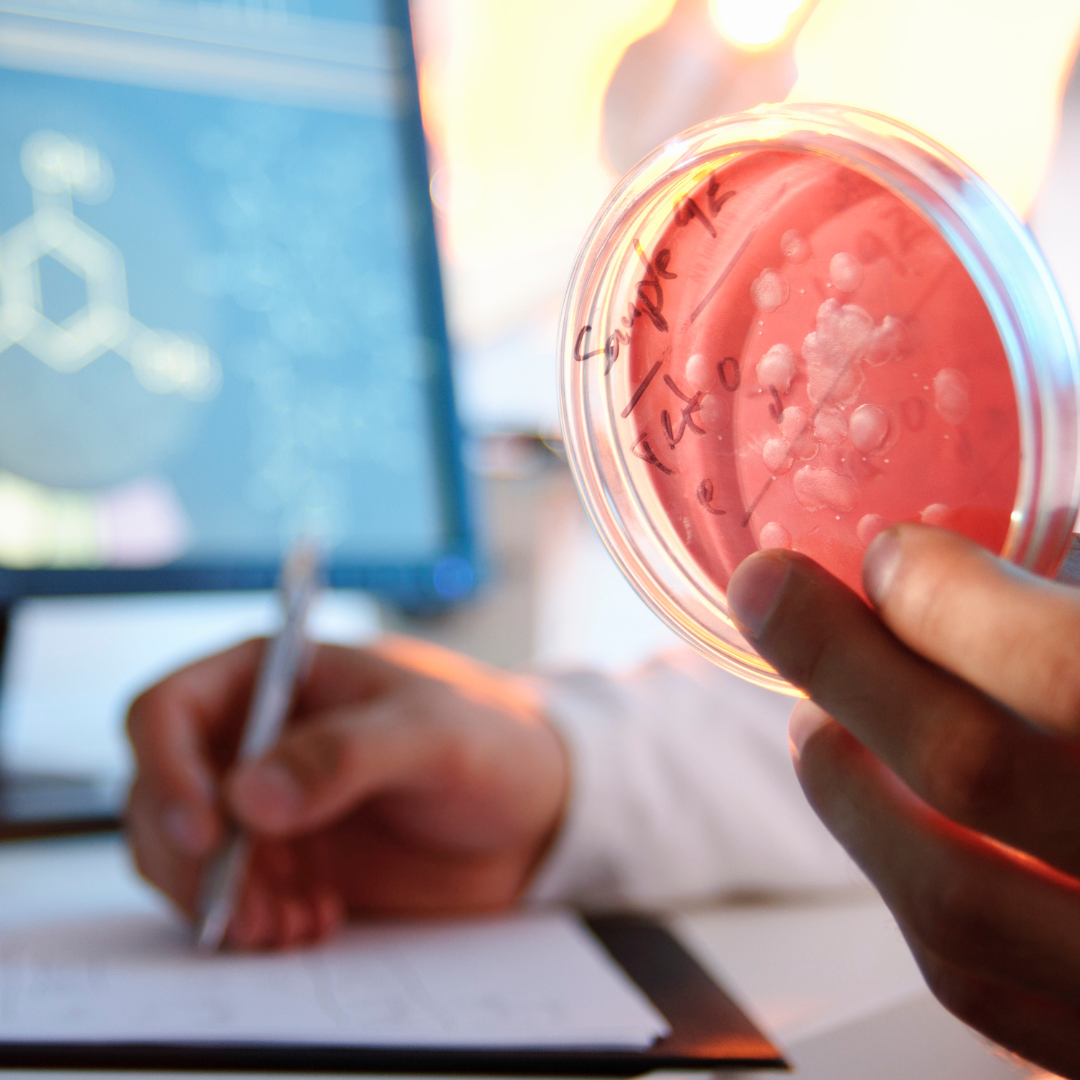

Medical Advices
& Check Ups
Trusted Medical
Treatment
Appointments
Available
Home Blood Collection
Please feel free to contact our friendly reception staff with any general or medical enquiry.
Improving the Quality of Life Through Better Health
At Healia Diagnostics, we understand that good health is the foundation of a fulfilling life. Our goal is to deliver quality care in a manner that is courteous, respectful, and compassionate. We aim to be your first and best choice for all your diagnostic and healthcare needs.
- We conduct a range of tests to help us work out why you're not feeling well and determine the right treatment for you.
- Our expert doctors, nurses and allied health professionals manage patients with a broad range of medical issues.
- We offer a wide range of care and support to our patients, from diagnosis to treatment and rehabilitation.
Our Laboratories
Haematology
Biochemistry
Microbiology
Immunology
Cytogenetic Analysis
Customized Diagnostic Packages
We understand that every patient has unique health concerns. That’s why we offer personalized diagnostic packages tailored to your specific needs. Whether you're coming in for a routine health screening or require advanced testing, our team ensures accuracy and clarity in every result. If specialized testing is required beyond our lab, we’ll provide trusted referrals to ensure you get comprehensive answers.
Reliable Laboratory Services
Our commitment is to deliver accurate, timely, and confidential lab results that support better health decisions. Serving doctors, clinics, and individuals, we ensure every test is processed using state-of-the-art equipment and protocols. With a focus on quality, safety, and patient care, we strive to be your trusted partner in diagnostics.
Trusted Diagnostic Solutions for Your Health Journey
Committed to Providing Safe, Accurate & Patient-Focused Diagnostic Care
Healia Diagnostics is dedicated to delivering high-quality diagnostic services tailored to individual health needs. From routine blood work to advanced imaging and health assessments, our mission is to ensure precise, timely, and confidential results empowering better health outcomes.
- Fracture & Dislocation Evaluations
- Desensitization Injection Testing
- Home-Based Medicine Reviews
- Comprehensive Health Assessments
- Commitment to High-Quality, Compassionate Care
Qualified Medical
Experts
Advanced Lab
Equipment
Accurate Test
Results
Your Trusted Partner in Health
Health Assessments
Regular health assessments are crucial for early detection and prevention of diseases. Our comprehensive health checkups are tailored to suit individuals of all age groups, helping you stay informed about your health status.
Chronic Disease Management
Managing chronic conditions requires consistent monitoring and personalized care. At Healia Diagnostics, we provide diagnostic tests and health evaluations to support effective disease management, empowering you to lead a better quality of life.
We Provide Reliable Diagnostic Services For Your Whole Family!
We collaborate with you to offer personalized diagnostic solutions, including regular screenings and advanced lab testing. If a service is not available, we’ll guide you with accurate referrals or expert advice. Your privacy and health are always handled with the highest standards of care.
- Blood & Urine Testing
- Health Check Packages
- ECG & Imaging Scans
- Home Sample Collection
- Allergy & Hormone Tests
- Quick & Accurate Reports
True Healthcare For Your Family!
Serve the community by improving the quality of life through better health. We have put protocols to protect our patients and staff while continuing to provide medically necessary care.
Inspiring Stories!
Sami Wade
ProminaHelping Patients From Around the Globe!!
Our staff strives to make each interaction with patients clear, concise, and inviting.
We provide a comprehensive range of plans for families and individuals at every stage of life.